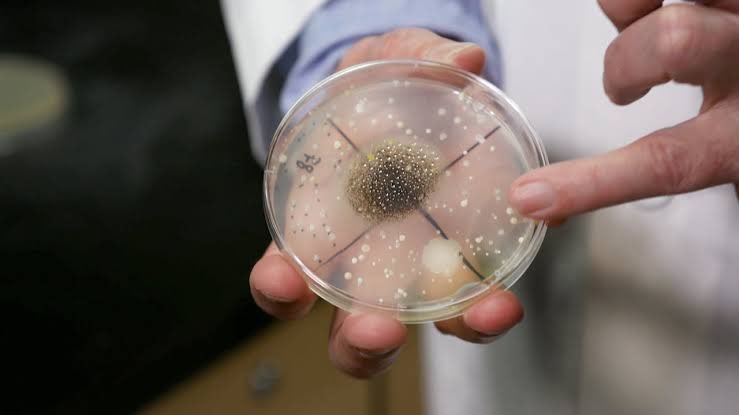
Ayman Alatas tweet media

Sabitlenmiş Tweet
cips
29.1K posts



@SukabumiiFess setau aku bisaa sih nder, btw sekalian promosi xixixi yg mau konseling gizi sm aku bolehh bgt bisa offline di klinik pemata ciaul / online juga bisa waktu nya fleksibel sebisa nya kalian🤗🤗
kalo di klinik permata senin-sabtu yaa jadwal nyaa!
Indonesia
cips retweetledi

I highkey agree with this. Soalnya aku pribadi gak mau punya pasangan yang nga ngebolehin aku kerja.
Dinafkahin memang enak, tapi punya penghasilan sendiri juga gak kalah nyamannya.
People change, kita gak bisa jamin kedepannya akan gimana. Kalau punya income sendiri, kita gak akan takut bgt2 krn udah secure.
Indonesia

@baesashimi @AymanAlatas bener bgt! aku sampe pernah luka di bibir perih bgt, setelah konsul ke dokter itu karna virus herpes yg tanpa sadar aku selaly ngebolegin tmn2 ku minta liptint, lipstik aku😖😖😖
Indonesia

@tanyarlfes @rawrcipa masih temenan ga sih kita? Itupun beda kelas sii
Indonesia

Jd all ingredients yg aku pake selalu premium yaaa🤗🤗
Buat PO pertama ini ready tgl 30, karna kepotong dulu lebaran xixixi. Yukkk order panjangin list nya bisa via WA atau DM yaaa! #sukabumi #sukabumifood #mochibites #mochisukabumi

Indonesia

Hiii! Setelah jadi tukang kue, kali ini aku mau bertransformasi jadi tukang mochi. Setiap buat orderan semua resep gaada yg aku ubah sama sekali, semua nya percis sama kyk buat dikonsumsi sendiri, entah itu dari gramasi atau merk produk nya! #sukabumi #sukabumifood #mochibites
Indonesia

@mantramuseum daerah mana nih kak? mau join dong kak buat bantu ngajar nya juga
Indonesia